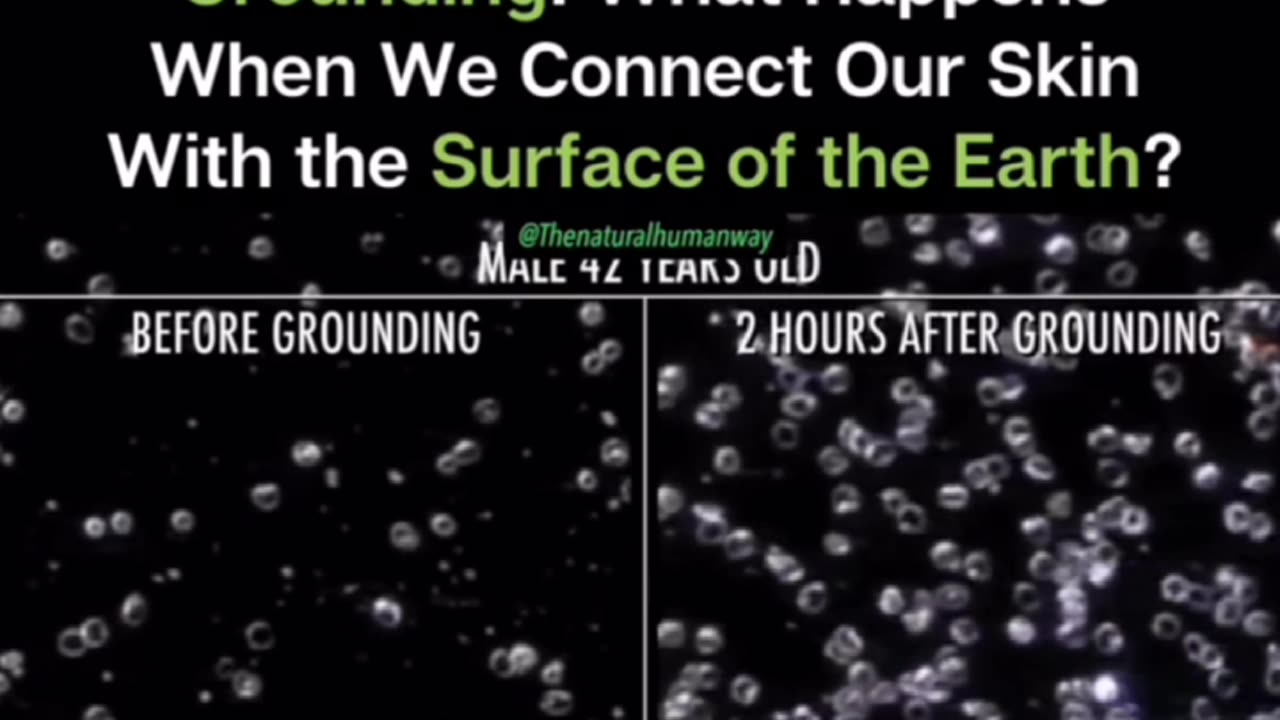

Premium Only Content
This video is only available to Rumble Premium subscribers. Subscribe to
enjoy exclusive content and ad-free viewing.
We Need To Touch The Earth
Loading comments...
-
 LIVE
LIVE
SilverFox
1 hour ago🔴LIVE - ARC AT NIGHT! COME THRU!
63 watching -
 LIVE
LIVE
Joker Effect
1 hour agoCLAVICULAR - What the hell is "Looks Maxing"? Asmond Gold is a Demon. KaceyTron. Steve Will do it.
450 watching -
 LIVE
LIVE
SlingerGames
47 minutes agoLIVE - Wumble Wednesday - BIRTHDAY STREAM!
20 watching -
 LIVE
LIVE
StevieTLIVE
1 hour agoWarzone Win Streaking BIG Challenges MASSIVE Hype NO Losses LOCK IN
20 watching -
 LIVE
LIVE
FrizzleMcDizzle
3 hours agoThis game is scary AF - RESIDENT EVIL 7
12 watching -
 1:03:47
1:03:47
TheCrucible
5 hours agoThe Extravaganza! EP: 66 (11/25/25)
74.6K12 -
 LIVE
LIVE
xxTOWERDOGxx
4 hours ago🦃Wobble Wobble, while you Gobble Gobble 🦃🟢Premium Creator🟢🪒No Shave November🪒
13 watching -
 2:02:38
2:02:38
Blabs Life
4 hours agoPART 4: Peter Jackson's King Kong: The Official Game of the Movie | Noob Plays
5.49K -
 1:16:43
1:16:43
BonginoReport
10 hours agoExposing Transgenderism w/ Amy Sousa - Nightly Scroll w/ Hayley Caronia (Ep.186)
127K23 -
 1:58:47
1:58:47
Redacted News
5 hours ago"What I saw in Ukraine SHOOK me to my core" Ukraine is not a democracy, it never was | Redacted
129K74